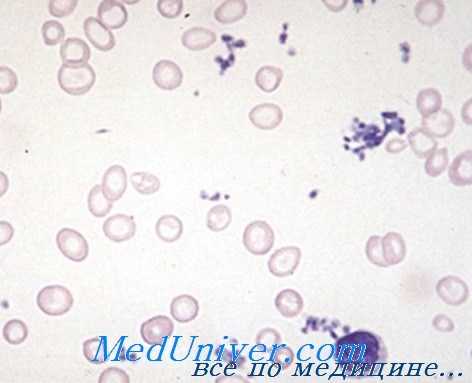
мазок крови при анемии

Клиническая диагностика анемии - признаки малокровия
Добавил пользователь Валентин П. Обновлено: 14.12.2025
Информацию из данного раздела нельзя использовать для самодиагностики и самолечения. В случае боли или иного обострения заболевания диагностические исследования должен назначать только лечащий врач. Для постановки диагноза и правильного назначения лечения следует обращаться к Вашему лечащему врачу.
Анемии: причины появления, симптомы, диагностика и способы лечения.
Определение
Анемия – это уменьшение содержания гемоглобина и/или снижение количества эритроцитов в единице объема крови, приводящее к снижению снабжения тканей кислородом.
Диагноз «анемия» ставят при снижении гемоглобина ниже 130 г/л у мужчин и ниже 115 г/л у женщин. У детей для постановки диагноза «анемия» принимают во внимание возраст ребенка.
Анемия встречается при ряде заболеваний (язвы и полипы желудочно-кишечного тракта, хроническая болезнь почек, онкологические, инфекционные заболевания, глистные инвазии и др). Чем ниже уровень гемоглобина, тем тяжелее протекает анемия.

Причины появления анемии
Анемия может возникнуть в результате нарушения образования эритроцитов, повышенного их разрушения или потери эритроцитов с кровью.
Статистика утверждает, что самой распространенной является анемия, возникшая после кровопотери (острой или хронической). Острой считается кровопотеря с объемом крови более 500-700 мл (у взрослых), которая происходит в течение короткого промежутка времени. Потеря крови может быть видимой (кровотечение из ран, кровавая рвота, маточное, носовое кровотечения) и первоначально скрытой (кровотечения в кишечник, в полость живота и/или плевры, большие гематомы).
Хронические кровопотери развиваются в результате незначительных, но длительных потерь крови (обильные и длительные менструации, язва желудка, рак, геморрой, проведение процедур гемодиализа и др.). С течением времени незначительные кровопотери приводят к истощению запасов железа в организме, когда количество теряемого организмом железа превышает его поступление с пищей. В результате дефицита железа нарушается синтез гемоглобина.

Каждый зрелый эритроцит покидает костный мозг с «комплектом» из 250-500 млн молекул гемоглобина. Молекула гемоглобина состоит из белковой части (четырех глобиновых субъединиц) и небелковой железосодержащей группы (гема). Основная биологическая функция гемоглобина – перенос кислорода от легких к тканям и транспорт углекислоты от тканей к легким. Продолжительность жизни эритроцитов составляет около 120 дней.

Дефицит железа может возникнуть из-за снижения всасывания железа в результате различных заболеваний двенадцатиперстной кишки и начальных отделов тонкой кишки (энтеритов, опухолей, состояний после оперативных вмешательств на данном участке кишечника). Состояния, приводящие к снижению уровня белков крови, являющихся переносчиками железа (нефротический синдром, нарушение белково-синтетической функции печени, синдром нарушенного всасывания, алиментарная недостаточность), также могут привести к его снижению и, как следствие, к анемии.
Железодефицитные анемии, связанные с исходно недостаточным уровнем железа (недостаток железа у матери в период беременности), наблюдаются у новорожденных и детей младшего возраста.
Анемии вследствие нарушенного кроветворения возникают:
- при недостаточном поступлении в организм или нарушении всасывания в желудочно-кишечном тракте компонентов, необходимых для образования эритроцитов (витамина В6, витамина В12, фолиевой кислоты и др.);
- поражении клеток костного мозга - предшественников эритроцитов токсическими веществами, ионизирующей радиацией;
- образовании вторичных очагов опухолевых клеток в костном мозге (метастазировании);
- нарушении синтеза небелковой части гемоглобина (гема) и накоплении его токсичных продуктов;
- нарушении регуляции образования эритроцитов (уменьшении продукции гормона, стимулирующего рост и размножение эритроцитов (эритропоэтин) или воздействии ингибиторов).
Развитие наследственных гемолитических анемий связано с генетическими дефектами (нарушением активности ферментов эритроцитов, нарушением структуры или синтеза гемоглобина, дефектами мембран эритроцитов).
Приобретенные гемолитические анемии могут быть обусловлены разрушением эритроцитов в результате воздействия на них антител, механических повреждений оболочки эритроцитов, химических повреждений эритроцитов, недостатка витаминов, разрушения эритроцитов паразитами.
Классификация анемий
1. Анемии, связанные с кровопотерей:
- анемии, связанные с нарушением образования гемоглобина;
- анемии, связанные с нарушением синтеза ДНК и РНК;
- анемии, связанные с нарушением процессов деления эритроцитов;
- анемии, связанные с угнетением пролиферации (размножения) клеток костного мозга.
- наследственные гемолитические анемии;
- приобретенные гемолитические анемии.
Существуют общие (неспецифические) проявления анемии и признаки, которые специфичны для определенного вида анемий.
К неспецифическим признакам анемии относятся бледность кожных покровов, слабость, повышенная утомляемость, сонливость, головокружение, обмороки, шум в ушах, мелькание «мушек» перед глазами, одышка, сердцебиение, учащенный пульс и др.
Отсутствие этих признаков не исключает наличие анемии, поскольку при легкой и среднетяжелой форме заболевания, а также его медленном развитии клиническая картина может быть смазанной.
Клинические проявления недостатка железа в организме: сухость кожи, нарушение целостности эпидермиса, ломкость ногтей, волос, изъязвления и трещины в углах рта, мышечная слабость. Может наблюдаться чувство жжения языка, извращение вкуса в виде неукротимого желания есть мел, зубную пасту, землю, сырую крупу, сырое мясо, а также пристрастие к некоторым запахам (ацетона, бензина).
Дефицит витамина В12 также может проявляться поражением желудочно-кишечного тракта (атрофическим гастритом) и неврологической симптоматикой (парестезиями, нарушением чувствительности, онемением конечностей). При крайне тяжелом течении заболевания наблюдаются психические нарушения, бред, галлюцинации, приобретенное слабоумие и др.
Клиническая картина дефицита фолиевой кислоты очень похожа на дефицит витамина В12, но при фолиеводефицитных состояниях отсутствует неврологическая симптоматика и редко возникает воспаление языка. Дефицит фолиевой кислоты приводит к обострению шизофрении, учащению и утяжелению приступов эпилепсии.
Для гемолитических анемий характерны желтушность кожных покровов и слизистых, увеличение размера селезенки, склонность к образованию камней в желчных путях.
При массивном гемолизе эритроцитов (гемолитическом кризе) кроме анемии, желтухи и ухудшения общего состояния могут наблюдаться тошнота, рвота, расстройство сознания, судороги, развитие острой почечной и/или сердечно-сосудистой недостаточности.
При апластической анемии, которая возникает на фоне угнетения пролиферации клеток костного мозга, происходят кровоизлияния (преимущественно в области бедер, голеней, живота, в местах инъекций образуются гематомы). Часто диагностируются бронхиты, пневмонии.
Диагностика анемии
Анемия может возникать под влиянием самых разнообразных факторов. Чаще всего встречаются дефицитные анемии (железодефицитные, B12-дефицитные, фолиеводефицитные и др.).
Большую роль в выявлении причины анемии играют сведения, полученные при опросе пациента: возраст, наличие профессиональных вредностей, характер диеты, наличие сопутствующих заболеваний, прием лекарственных препаратов, информация о наследственности и др. Не менее важны данные осмотра: изменение цвета и состояния кожи; увеличение лимфатических узлов, печени, селезенки; наличие поражения нервной системы.
Первый этап диагностики анемии обычно включает следующие исследования:
- клинический анализ крови: определение концентрации гемоглобина, количества эритроцитов, лейкоцитов, величины гематокрита и эритроцитарных индексов (MCV, RDW, MCH, MCHC), лейкоцитарной формулы и СОЭ (с микроскопией мазка крови при наличии патологических сдвигов);
Синонимы: Общий анализ крови, ОАК. Full blood count, FBC, Complete blood count (CBC) with differential white blood cell count (CBC with diff), Hemogram. Краткое описание исследования Клинический анализ крови: общий.
Клиническая диагностика анемии - признаки малокровия
Значительная частота анемий и разнообразие их этиопатогенетических форм создают, в процессе диагностирования, существенные проблемы для каждой медицинской специальности в отдельности. Для правильной ориентации в постановке клинического диагноза следует начать отождествлением общих признаков синдрома анемии и определением характерных симптомов отдельных групп или видов анемии.
Объективное клиническое обследование необходимпо связать с данными анамнеза, которые дают сведения о начале заболевания, его течении и отдельных этиологических условиях, при которых можно распознать специфические факторы развития анемии.
Клиническое объективное исследование, дополненное признаками субъективного страдания выявляет некоторую общую характеристику, в том числе:
1) бледность покровов и соединительной ткани;
2) физическая и умственная утомляемость, раздажительность или сонливость — как общее воздействие на обмен веществ и нервную систему в результате недостаточной оксигенации тканей;
3) сердечно-сосудистые и сердечно-дыхательные признаки за счет приспособительного и компенсаторного усилий, причем интенсивность колеблется в зависимости от тяжести анемии и ее течения.
Эти общие признаки проявляются резко при острых тяжелых анемиях (расплавление крови или кровотечение) с сокращением массы эритроцитов, что определяется понижением показателя гематокрита до менее 45%. При этом падение давления артериального кислорода резко отражается на ткани, а затем и на весь организм, и проявляется компенсаторной реакцией.
При медленно развивающейся анемии и постепенном сокращении гемоглобина сердечно-дыхательные адаптационные механизмы способствуют общему приспособлению организма и падению кислородного давления, в связи с чем общие тяжелые признаки появляются позже, постепенно, после значительных сокращений постоянных эритроцитов. Для клинициста картина анемии с общими тяжелыми признаками, после потери крови путем ее расплавления или острого кровотечения, резко отличается от медленно развивающейся хронической анемии — как при болезни Бирмера —, и которая совместима с удовлеворительным образом жизни при больших понижениях показателя гемоглобина.
При анемии сердечнососудистые нарушения образуют особый синдром, исходно проявляющийся тахикардией, головокружением и обморочным состоянием, вплоть до крупного геморрагического или гемолитического шока, который наступает резко в условиях крупной потере эритроцитной массы. В случае геморрагии синдром определяют пониженное общее количество сосудистой крови и ее разжижение, в то время как при расплавлении крови — нагрузка продуктами гемолиза.
Однако недостаточная оксигенация вызывает, в любой из форм, сердечно-сосудистые нарушения функционального характера, определяемые резким уменьшением гемоглобина.

Диаграмма физиологических адаптационных реакций, в зависимости от убавления гемоглобина при анемии (по Wintrobe)
На диаграмме, воспроизведенной по Wintrobe функциональные нарушения это результат сочетания реактивных компенсаторных процессов и сокращения других функциональных параметров. При хронических формах к этим функциональным нарушениям постепенно присоединяются расстройства, вызванные дегенеративным поражением миокарда и других паренхим, в зависимости от вида анемии.
При бирмеровской ">анемии, длительного течения, развиваются сердечно-дегенеративные процессы за счет продолжительности анемии и комплексности метаболической недостаточности. Дегенеративные явления миокарда развиваются и при сидероаккрестических и апластических анемиях длительного течения.
В этих двух группах, равно как и при гемолитической анемии за счет гемоглобинопатии развивается диффузный гемосидероз с отложением железного пигмента в сердечной мышце, легких, сердечной сорочке, печени, поджелудочной железе, в результате чего наблюдается дегенеративный процесс и недостаточность, которые постепенно усугубляются с поражением этих органов. Вторичный гемохроматоз это результат отложения железа, количество которого в сосудистой крови увеличивается в связи с его отделением в процессе выраженного хронического расплавления крови и повторными переливаниями.
В случае костномозговой аплазии чрезмерная нагрузка железом представляется как следствие его неиспользования костным мозгом и повторных переливаний. Лабораторные исследования должны уточнить природу анемии с чрезмерной нагрузкой железом и интенсивность гемохроматоза.
Кроме общих признаков, меняющихся в зависимости от интенсивности анемии и ее резкого или медленного развития, существует также характерная каждому этиопатогенетическому виду анемии симптоматология. Отличительные признаки специальных групп обусловлены определяющими их этиопатогенетическими механизмами и сочетания отдельных симптомов и сопровождающих их особых осложнений.
При гипохромной гипосидеремической анемии — в принципе вторичной — отождествляются связанные с первичным заболеванием признаки, такие как хроническое кровотечение (из пищеварительного тракта, матки, легких, почек и пр.), хроническая инфекция, неопластическое заболевание или особое физиологическое состояние, требующие увеличенного подвоза железа (периоды роста, половой зрелости, беременности, вскармливания грудью). Дополнительно отмечаются кожные признаки за счет недостатка железа с дегенеративными расстройствами в виде роговых образований и особая бледность, подобная той, которую встречаем у страдающих хлорозом молодых вообще, и женщин в возрасте менопаузы.

Бледные кожные покровы - как признак анемии
Виды гипохромной гиперсидеремической, кажущейся эссенциальной, анемии подвергаются исследованию в целях уточнения вида гиперсидеремии, отграничивая вторичные формы при инфекции, генуинной сидероаккрестической анемии и талассемии.
В группе мегалобластических анемий — при первичных формах болезни Бирмера за счет недостатка витамина В12, бледность уступает место желтому оттенку поджелтушного состояния, в связи с импрегнацией желчными пигментами по причине наблюдаемого при этом заболевании хронического умеренного расплавления крови.
Признаки хронического расплавления крови, сопровождающие хронические гемолитические эндо- или экзоэритроцитные анемии отличаются от тех, которые наблюдаются при мегалобластической бирмеровской анемии, к которой присоединяются симптомы атрофии пищеварительного тракта, отсутствие сосочков языка, ахилия и нервные признаки, обусловленные поражением переднебоковых канатиков.
Группа гемолитических анемий характеризуется несколькими общими клиническими признаками, определяемыми нарушением за счет продуктов гемолиза. При остром расплавлении крови помимо резко наступающего синдрома анемии, которому, в определенных случаях, сопутствует шоковое состояние, развиваются гемоглобинурия и гемосидерурия. Хроническому расплавлению крови — в условиях умеренной анемии или даже без таковой — сопутствует желтушный синдром с гепатоспленомегалией, резко окрашенными испражнениями и мочой коричневого цвета в связи с выделением уробилина.
В условиях не резко выраженной анемии общее состояние хорошее. Однако, в отдельных случаях, появляются признаки тромбоза периферических вен или центрального тромбоза внутренних органов. В принципе врожденные хронические ондоэритроцитные анемии, в том числе за счет микросфероцитоза, гемоглобинопатии сопровождаются дистрофией костей, особенно с пороками черепа.
Гемолитическая анемия за счет знзимопатии редко обнаруживается как клиническое заболевание, чаще она является результатом воздействия отдельных окисляющих гемоглобин химических факторов, к которым относятся медикаментозные препараты.
Иммунологическая гемолитическая анемия не отличается особой клинической характеристикой, в связи с чем ее природа определяется по специфическим иммунологическим факторам, которые обусловливают либо острое, либо, в основном, хроническое расплавление крови.
Редактор: Искандер Милевски. Дата обновления публикации: 18.3.2021
Анемии
Лабораторная диагностика анемии в гематологии - методы исследования
Лабораторно-диагносточеский подход при синдроме анемии. Приведенная ниже патогенетическая классификация составляет основной материал в деле диагностирования анемии. Группировка анемий по морфологический критериям в результате гематологических исследований представляет собой одно из диагностических направлений, которое, однако, следует связать с этиопатогенетическими механизмами.
Диагноз этиопатогенетической формы осуществляется классическими исследованиями периферической крови и костного мозга во взаимосвязи с данными частных биологических исследований. Хорошо ориентирующийся в проблеме этиопатогенеза анемий клиницист запрашивает в лаборатории поэтапное проведение исследований при сопоставлении результатов которых уточняется правильное диагностическое определение.
Целью поэтапного исследования является, в первую очередь, определение синдрома анемии, как такового, затем ее этиопатогенетическую форму, тяжесть и течение.
Диагностирование синдрома анемии проводится на основе известных исследований периферической крови, таких как, определение гемоглобина, массы красных кровяных телец путем их подсчета, или, особенно, уточнением гематокрита. Это перечисление следует дополнить частными исследованиями красных кровяных телец и определением их показателей, в том числе диаметра, объема, количества гемоглобина на каждое красное кровяное тельце, процент нагрузки гемоглобином.
Морфологические сдвиги, уточненные исследованием окрашенных по Май-Грюнвальду-Гимза мазков, представляют особую ценность. Морфология эритроцитов указывает на быстроту их восстановления, нагрузку гемоглобином, а в отдельных случаях и на наличие патологического гемоглобина, как, например, при талассемии, дрепаноцитозе и т.д.

Патогенетическая классификация анемий
Довольно четко выделяются следующие виды анемии:
1) регенеративная — с молодыми красными кровяными тельцами, полихроматофилией, анизохромией, кольцами Кабо, базофильными точками; при этом рост ретикулоцитов более 2,5—3% составляет признак анемии по периферической причине, за счет геморрагии или гемолиза;
2) гипорегенеративная — за счет аплазии костного мозга, при которой выявляются состарившиеся красные кровяные тельца, в принципе нормохромные и нормоцитные, без признаков регенерации и заниженным ретикулоцитозом;
3) группа классических анемий, за счет недостатка созревания, по виду бирмеровской или железодефицитной анемии, которые, с точки зрения кроветворения также гипорегенеративные. Периферическое исследование выявляет особую характеристику красных кровяных телец мегалобластической группы с наличием макрофагов и мегалоцитов, пойкилоцитоза, а в отдельных случаях почти патогномоничное присутствие мегалобластов.
В отношении гипохромной анемии, независимо от причины, вообще обнаруживаются микроциты с анизоцитозом, также характерное наличие аннулоцитов с периферическим расположением гемоглобина. Эритроцитные показатели свидетельствуют о небольшом содержании гемоглобина, в то время как заниженный ретикулоцитоз составляет признак гипорегенерации. Наличие пигмента железа в красных кровяных тельцах отличает гипосидеремическую гипохромную анемию от сидероакктрестической.
Морфологическое исследование костного мозга уточняет следующие виды миелограммы:
1) апластический или гипопластический костный могз, характерный апластичеокой анемии;
2) гиперпластический костный могз, охватывающий два вида:
а) активный регенеративный гиперпластический костный мозг со всей эритробластической филиацией и явными признаками созревания по виду ретикулоцитов — характерный гемолитической анемии всех видов и анемии с острыми кровотечениями (анемии периферической природы);
б) гиперпластический костный мозг с множеством молодых клеток, преобладание которых указывает на недостаточность созревания; при этом различаются макромегалобластический или мегалобластический вид — подобно анемии Бирмера, эритробласти-ческий вид — как при гипохромной анемии,
Следует отметить, что макробластические отклонения наблюдаются при отдельных острых или хронических гемолитических анемиях за счет расхода факторов созревания, в то время как мегалобластические — при ночной пароксизмальной гемоглобинурии, сидероаккрестических и прочих анемиях сложной зтиологии, описанных под названием дисэритропоэтических анемий с гигантскими мегалобластами.
Специальные биологические исследования составляют обязательный этап в процессе постановки этиопатогенетического диагноза отдельных видов анемии. Эти исследования проводятся комплексными методами путем сотрудничества клинициста, морфолога, биохимика и иммунолога. В каждой группе преобладает тот или иной вид частных исследований.
Как уже говорилось, во многих анемиях морфологические периферические и центральные исследования достаточны для постановки диагноза, как, например, при апластической анемии, с дополнительной биопсией костного мозга. Некоторые исследования общего характера, организуемые на основе данных анамнеза, стремятся уточнить этиологическую — токсическую, инфекционную, раковую или пр. природу аплазии костного мозга.
Так, исследование интенсивности и скорости метаболизма железа предоставляет ценный материал, по которому определяется неспособность костного мозга использовать железо и откладывать его в отдельные органы.
Мазок крови при анемии
При других анемиях, как описано ниже, частные исследования необходимы для уточнения их этиопатогенетической природы.
1) Диагностика гемолитической анемии. На первом этапе при помощи исследования расплавления крови, уточняются: гипербилирубинемия, уробилинурия, повышенный показатель стеркобилина, гиперсидеремия, с увеличенными интенсивностью и скоростью метаболизма железа; иногда невысокая устойчивость кровяных клеток — как, например, при микросфероцитозе и повышенном аутогемолизе; при этом продолжительность жизни красных кровяных клеток невелика в любом из видов гемолитической анемии.
На следующем этапе частные исследования стремятся уточнить природу расплавления крови (путем эндо- или экзоэри-троцитного механизма). Так, уточняется диагностика микросфероцитоза, гемоглобинопатии или энзимопатии сопоставлением морфологических периферических сдвигов и осмотической устойчивости, аутогемолиза, методами определения гемоглобина и прямыми или косвенными испытаниями, уточняющими ферментативную недостаточность.
Наличие телец Гейнца, характерно гемолитическим анемиям за счет гемоглобинопатии, отдельных энзимопатии или токсических факторов окислительного действия на гемоглобин. Среди гемолитических экзоэритроцитных анемий особую характеристику представляют те из них, которые обусловлены свинцовым отравлением. Особо важную группу составляют изоиммунные и аутоиммунные гемолитические анемии, которые исследуются правильным применением прямой или косвенной техники Кумбса с сыворотками антигамма и антинонгамма, в теплых и холодовых условиях.
Специальные методы требуются в постановке диагноза гемолитической анемии за счет сенсибилизации к медикаментам, что определяется тестами гемолиза, в том числе реакцией Кумбса, в присутствии сенсибилизирующих препаратов.
2) Диагностика анемии за счет острого кровотечения предполагает общее исследование для уточнения внутреннего кровотечения по местным, висцеральным (язва или рак желудка, разрыв аневризмы) или общим (в рамках геморрагического, фибриногенопенического, воротногипертензивного и пр. синдромов) причинам.
3) Группа анемий за счет недостаточности созревания. Когда морфологические исследования оказываются недостаточными, необходимо прибегнуть к частным исследованиям. Так, в бирмеровской и парабирмеровской группах анемии подвергаются исследованию недостаточность выделения желудочного сока, отсутствие фактора Castle с помощью реакции Шиллинга.
В хорошо оснащенных лабораториях высокая точность диагноза достигается биологическими или радиохимическими методами в целях определения циркуляции витамина В12 и фолиегой кислоты.
4) Гипохромная анемия. Помимо текущих исследований в отдельных случаях необходимо использование и частных методов определения механизма гипохромии. Так, проводится исследование интенсивности и скорости метаболизма железа, уточняется плазматический раздел с определением трансферина, предельной насыщаемости, способности резорбции слизистой оболочкой желудка.
Затем определяются загрузка железом и его отложения в РЭС или сидеробластах, используя на то метод прямой окраски в костном мозге или радиоактивные способы.
Поэтапное проведение этих исследований входит в обязанности обычных гематологических лабораторий, которые уточняют диагностику значительного числа анемий, включительно гемолитических аутоиммунных, а косвенными способами даже гемолитических, обусловленных гемоглобине- и энзимопатией.
Применение частных способов, таких как определение продолжительности жизни, интенсивности и скорости метаболизма железа, электрофоретическая характеристика определенного патологического гемоглобина, недостаточности отдельных эритроцитных ферментов, циркуляции витамина В12 и фолиевой кислоты — возлагаются на высокоспециализированные лаборатории. Перед назначением специфической терапии рекомендуется использовать все виды исследования в целях устранения любой возможной нечеткости.
Неоправдывающие себя лечения витамином В12 и фолиевой кислотой, равно как и кортизонотерапия или лечение иммуносупрессорными средствами при предполагаемых аутоиммуных анемиях в значительной мере способствуют не правильному диагностированию заболевания.
Читайте также:
- Липидный обмен при сахарном диабете. Обмен холестерина при диабете
- Патология вестибулярного анализатора. Исследование уха
- Воздействие старения на сердце и кровеносные сосуды
- Методика операции при параличе лицевого нерва и ее эффективность
- Проба с дозированной физической нагрузкой. Нагрузка при спирометрии
